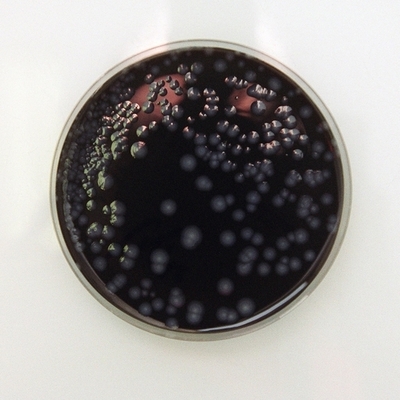
英エディンバラのレジオネラ菌感染、死者2人に

UK
-

もっとファッションに気を使って!ザック・ポーゼンからの提案
-

モニカ・ベルッチ、リップスティックはメイクアイテム最大の武器
-

ウィキリークス創設者のアサンジ容疑者、エクアドルに亡命申請
-

ケイト・モス、ジョージ・マイケルの新曲ビデオに出演?!
-

エマ・ストーン、レッドカーペットのスタイルはスタイリストにお任せ
-

ジゼルが記録更新、「フォーブス」のモデル所得番付で6年連続1位に
-

リアム・ギャラガー、自分に似合うものがわからない人は“かわいそう”
-

ポール・マッカートニーが70歳に、引退の気配なし 五輪でも演奏予定
-

そのハト、ちょっと大きすぎない?英ロンドン名物の電話ボックスがアートに
-

ロレンゾが英国GP制し3連勝
-

<13年春夏ロンドン・メンズコレクション>プリングル オブ スコットランド
-

英エディンバラのレジオネラ菌感染、死者2人に
-

ダライ・ラマ14世が英国訪問、初日はラッセル・ブランドと共演
-

「いまいち給食」ブログ、禁止騒動でいっそう人気に
-

五輪チケットを不正売買か、IOCが調査を開始
-

イングランドのホジソン監督、ルーニー復帰を明言
-

レディー・ガガ、米「ヴォーグ」9月号の表紙に
-

サラ・ジェシカ・パーカー、娘のためにフェンディの「バゲット」を保管